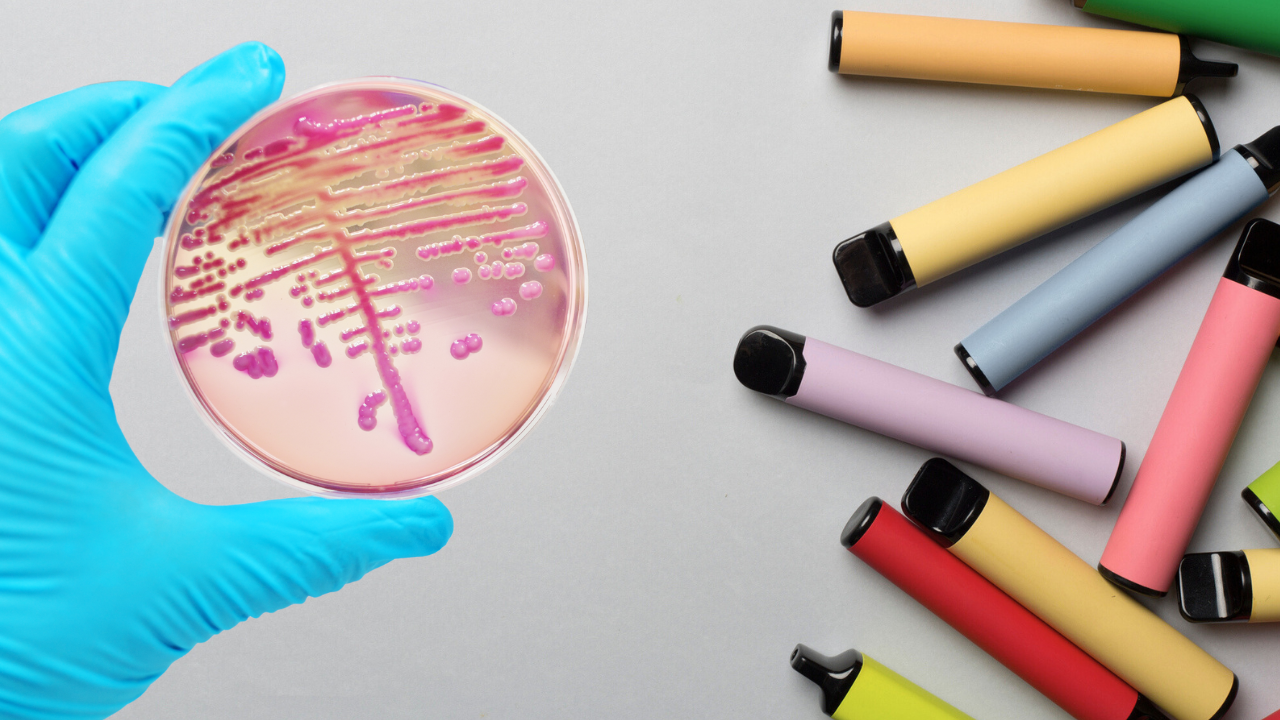
E-Cigarettes Carry Fecal Bacteria Like E. Coli And More, More Details Inside

E-Cigarettes Carry Fecal Bacteria Like E. Coli And More, More Details Inside
Credits: iStock and Canva
SummaryA new study shows vape mouthpieces carry extremely high bacterial contamination, including fecal bacteria like E. coli. Researchers found up to 2,300 times more microbes on vapes than on public toilet seats, largely due to poor cleaning, frequent handling and even bathroom use. Bacterial growth begins within a day and intensifies over two weeks.
End of Article
